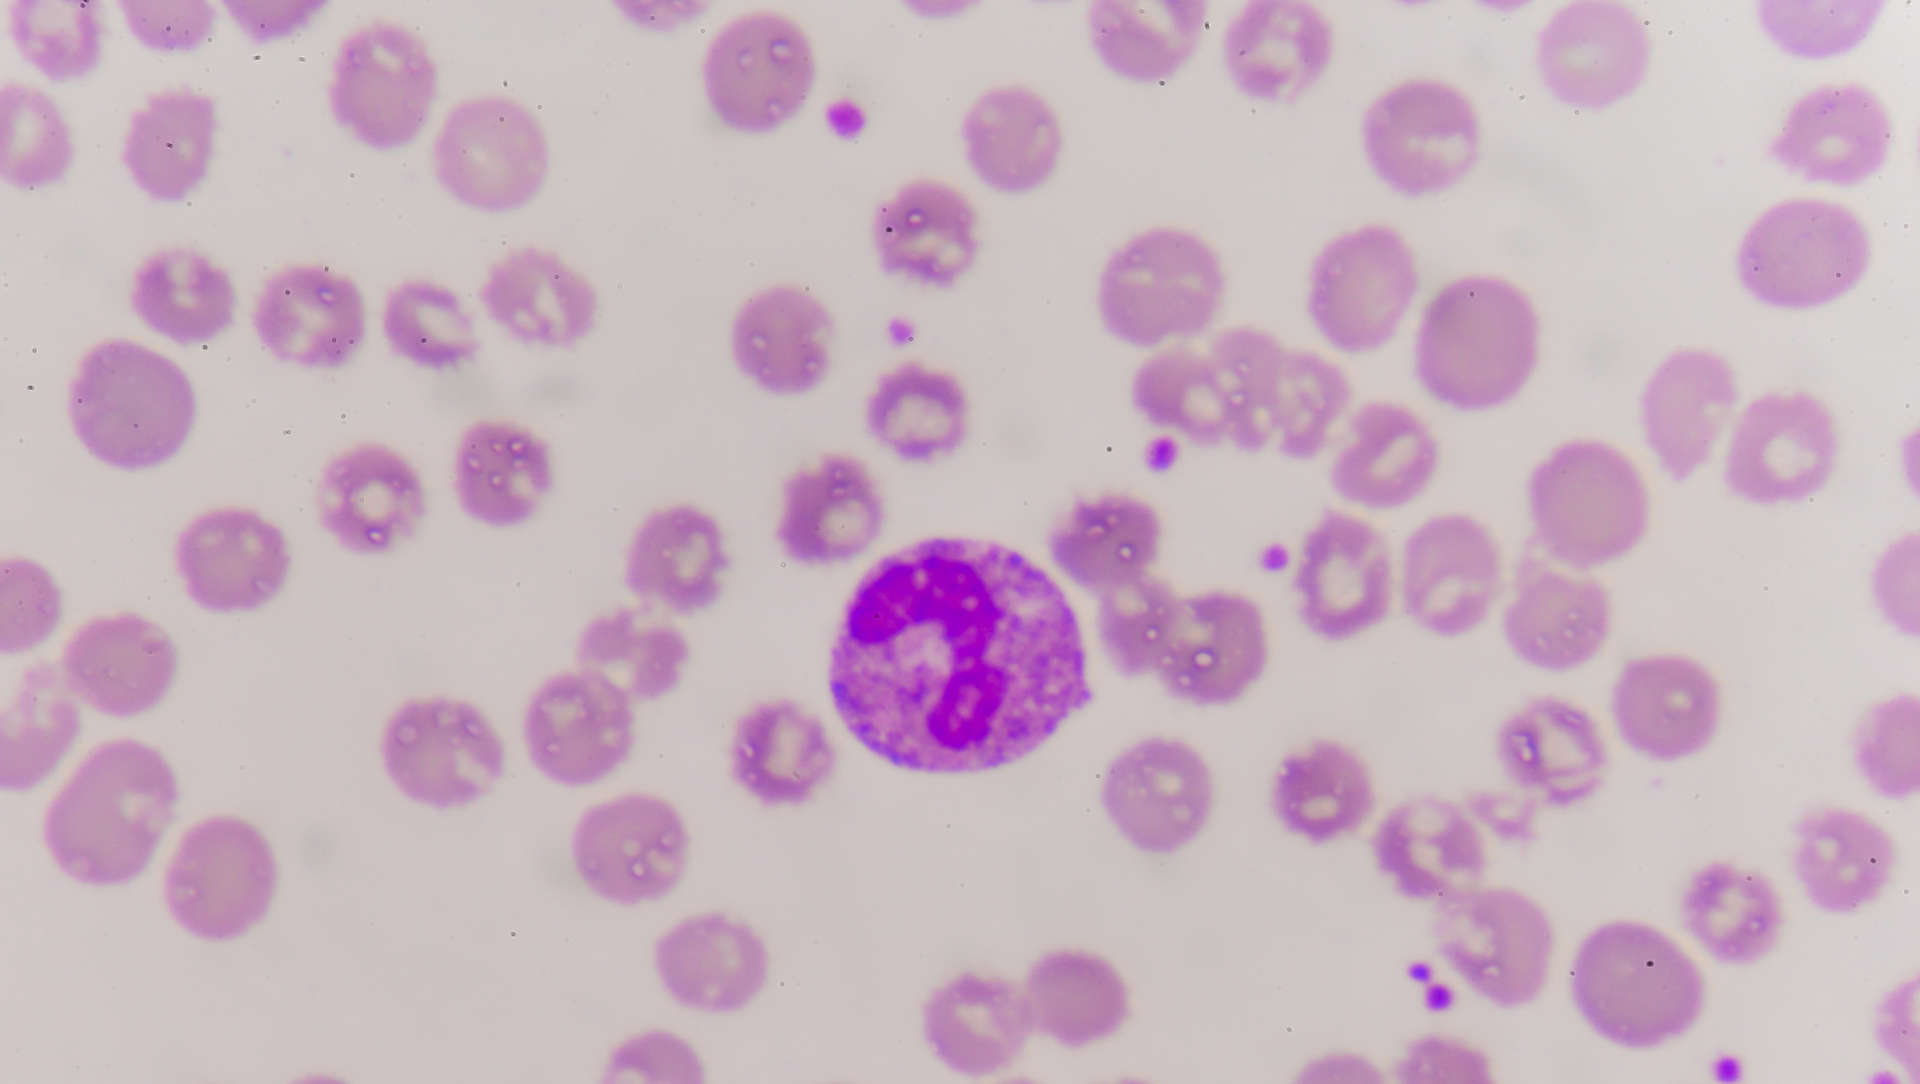
Blood film showing bacteraemia

Publication
- Title: Fast Antimicrobial Susceptibility Testing for Gram-Negative Bacteremia: The FAST Randomized Clinical Trial
- Acronym: FAST
- Year: 2026
- Journal published in: JAMA
- Citation: Banerjee R, Komarow L, Li Y, et al. Fast Antimicrobial Susceptibility Testing for Gram-Negative Bacteremia: The FAST Randomized Clinical Trial. JAMA. Published online April 18, 2026.
Context & Rationale
-
Background
- Gram-negative bacteraemia is common, time-critical, and increasingly shaped by cephalosporin and carbapenem resistance, so delays in definitive susceptibility data can delay both escalation to active therapy and de-escalation of unnecessary broad-spectrum treatment.
- Earlier prospective randomised studies of rapid bloodstream susceptibility testing generally shortened time to optimal or active therapy without clearly reducing mortality or length of stay; most were done in lower-resistance, largely high-income settings, leaving uncertainty about whether rapid phenotypic AST (antimicrobial susceptibility testing) would matter more where empiric mismatch is common. 123
- FAST was deliberately positioned in centres with high endemic antimicrobial resistance, where the biological opportunity for benefit should have been greatest.
-
Research Question/Hypothesis
- Among hospitalised adults and children with gram-negative bacillary bloodstream infection, does rapid phenotypic AST performed directly from positive blood cultures, in addition to standard testing and stewardship review, improve 30-day patient-centred outcomes compared with standard AST alone?
- The superiority hypothesis was framed as a more favourable day-30 DOOR distribution in the rapid-testing arm.
-
Why This Matters
- This was the clinically most plausible use-case for rapid AST: resistant pathogens were frequent, undertreatment was a realistic risk, and stewardship teams could act quickly on more timely phenotypic data.
- If rapid AST could not improve outcomes here, its benefit in lower-resistance or less well-supported settings would be even less certain.
Design & Methods
- Research Question: Does rapid phenotypic antimicrobial susceptibility testing performed directly from positive blood culture bottles improve 30-day clinical outcomes, compared with standard susceptibility testing, in hospitalised patients with gram-negative bacteraemia managed in real-world, high-resistance settings?
- Study Type: Open-label, multicentre, multinational, randomised, superiority trial conducted at 7 hospital centres in Greece, Israel, India, and Spain; enrolment occurred from December 2023 to May 2025, with follow-up through June 18, 2025.
- Population:
- Hospitalised adults and children with gram-negative bacilli seen on blood culture Gram stain.
- Randomisation had to occur within 16 hours of blood culture positivity.
- Key exclusions: gram-negative bacilli in blood culture within the previous 7 days; death at the time of blood culture result; Gram stain showing gram-positive bacilli, gram-positive cocci, gram-negative cocci, yeast, fungi, or mixed gram-negative morphologies; prior enrolment.
- Intervention:
- MALDI-ToF organism identification as in both arms.
- Rapid phenotypic AST performed directly from positive blood culture contents using VITEK REVEAL, in addition to standard AST on subcultured bacteria.
- Rapid AST results were released into the medical record and/or communicated directly to clinicians by telephone or secure messaging when available.
- All patients also underwent review by local antimicrobial stewardship teams, which could recommend escalation, de-escalation, dose optimisation, or route change.
- Comparison:
- Standard AST alone on subcultured bacteria, using site-specific methods (including VITEK 2, Phoenix, Microscan, or disk diffusion depending on site), plus routine MALDI-ToF identification.
- The same stewardship review process operated in the control arm, so the experimental contrast was faster phenotypic susceptibility data rather than stewardship itself.
- Blinding: Open-label. Treating clinicians were unaware of allocation at the time of randomisation, so initial empiric therapy was not influenced by group assignment; however, stewardship teams, laboratory staff, and outcome assessors were unmasked thereafter.
- Primary outcome (DOOR): Desirability of Outcome Ranking (DOOR) is an ordinal, patient-centred 30-day composite with 3 ranked categories: alive without deleterious events, alive with ≥1 deleterious event, and death; treatment effect is summarised as the probability that an outcome in the rapid AST group is more desirable than one in the standard AST group.
- Statistics: A total of 900 patients were planned (405 evaluable per group, allowing 10% unevaluable) to detect a DOOR probability of 55% versus the null 50% with 80% power at a one-sided 2.5% significance level. Primary and secondary analyses were performed as randomised, excluding prespecified unevaluable patients identified after randomisation (modified intention-to-treat / as-randomised population).
- Follow-Up Period: 30 days after randomisation, or until death or discharge if earlier.
Key Results
This trial was not stopped early.
| Outcome | Rapid AST | Standard AST | Effect | p value / 95% CI | Notes |
|---|---|---|---|---|---|
| Primary outcome: DOOR at day 30 | 196/413 (47%) alive without deleterious events; 117/413 (28%) alive with ≥1 deleterious event; 100/413 (24%) dead |
216/437 (49%) alive without deleterious events; 122/437 (28%) alive with ≥1 deleterious event; 99/437 (23%) dead |
DOOR probability 48.8% | 95% CI 45.3 to 52.4 | Superiority required the lower CI bound to exceed 50%; criterion not met. |
| DOOR with hospital stay / time-to-death tiebreaker | Same 3-category distribution | Same 3-category distribution | DOOR probability 49.5% | 95% CI 45.6 to 53.3 | Sensitivity analysis; still nonsuperior. |
| All-cause 30-day mortality | 100/413 (24.2%) | 99/437 (22.7%) | Risk difference +1.6% | 95% CI −4.1 to 7.3 | No mortality benefit. |
| Days from enrolment to discharge | Median 8 days (95% CI 7 to 8) | Median 8 days (95% CI 7 to 9) | Median difference 0 days | 95% CI −1 to 1 | No overall length-of-stay effect. |
| Still hospitalised at 30 days | 38/413 (9.2%) | 58/437 (13.3%) | Risk difference −4.1% | 95% CI −8.3 to 0.2 | Favoured rapid AST numerically, but CI crossed 0. |
| Effective antibiotic therapy within 24 hours | 345/413 (83.5%) | 329/437 (75.3%) | Risk difference +8.2% | 95% CI 2.9 to 13.6 | Early active therapy improved. |
| Effective antibiotic therapy within 3 days | 365/413 (88.4%) | 374/437 (85.6%) | Risk difference +2.8% | 95% CI −1.7 to 7.3 | Difference narrowed by 72 hours. |
| Hours from Gram stain to effective therapy within 3 days | Median 0 h (95% CI NE to NE) | Median 0 h (95% CI NE to NE) | Median difference 0 h | Not estimable | More than half of patients in both arms were already on effective therapy at baseline. |
| Hours from Gram stain to first escalation or de-escalation | Median 22 h (95% CI 14 to 25) | Median 36 h (95% CI 30 to 45) | Median difference −14 h | 95% CI −22 to −6 | Clear overall process-of-care benefit. |
| Stewardship recommendation within 3 days | 314/413 (76.0%) | 255/437 (58.4%) | Risk difference +17.7% | 95% CI 11.5 to 23.9 | Exploratory process outcome. |
| Stewardship recommendation accepted within 2 days | 287/413 (69.5%) | 239/437 (54.7%) | Risk difference +14.8% | 95% CI 8.4 to 21.2 | Exploratory process outcome. |
| Kidney failure | 21/413 (5.1%) | 34/437 (7.8%) | Risk difference −2.7% | 95% CI −6.0 to 0.6 | No signal of excess renal harm. |
| Acquisition of multidrug-resistant organism | 55/413 (13.3%) | 51/437 (11.7%) | Risk difference +1.6% | 95% CI −2.8 to 6.1 | No clear difference; C difficile was 2.2% vs 3.0%. |
| Cephalosporin-resistant subgroup: days to discharge | Median 8 days (95% CI 7 to 12) | Median 11 days (95% CI 9 to 13) | Median difference −3 days | 95% CI −6 to 0 | Prespecified subgroup. |
| Cephalosporin-resistant subgroup: hours to first escalation or de-escalation | Median 12 h (95% CI 10 to 18) | Median 35 h (95% CI 27 to 47) | Median difference −23 h | 95% CI −34 to −12 | Prespecified subgroup. |
| Carbapenem-resistant subgroup: still hospitalised at 30 days | 13/86 (15.1%) | 21/75 (28.0%) | Risk difference −12.9% | 95% CI −25.6 to −0.2 | Prespecified subgroup; one of the clearest clinical signals. |
| Carbapenem-resistant subgroup: hours to effective therapy within 3 days | Median 9.5 h (95% CI 3 to 13) | Median 28 h (95% CI 1 to 50) | Median difference −18 h | 95% CI −42 to 6 | Numerically favoured rapid AST, but imprecise. |
| Carbapenem-resistant subgroup: hours to first escalation or de-escalation | Median 13 h (95% CI 10 to 21) | Median 47 h (95% CI 32 to 57) | Median difference −29 h | 95% CI −44 to −14 | Prespecified subgroup. |
- The primary superiority test was negative: the DOOR estimate sat below the neutral 50% threshold, and the 95% CI crossed 50% in both the primary and tiebreaker analyses.
- Rapid AST produced clear treatment-process separation: effective therapy within 24 hours was 83.5% vs 75.3%, and first escalation/de-escalation occurred 14 hours earlier overall.
- Interpretation is complicated by open-label DOOR component ascertainment and by unequal post-randomisation exclusions from the primary analysis: 37/450 (8.2%) in rapid AST vs 12/449 (2.7%) in standard AST.
Internal Validity
- Randomization and Allocation: Randomisation was 1:1, stratified by site and ICU status at the time of Gram stain result, using permuted blocks of 4. Treating clinicians were unaware of assignment at the moment of randomisation, which reduced contamination of the initial empiric antibiotic decision.
- Drop out or exclusions: Of 899 randomised patients, 850 entered the primary analysis. Post-randomisation exclusion was asymmetric: 37/450 (8.2%) in the rapid arm versus 12/449 (2.7%) in the standard arm. In the rapid arm, exclusions included 30 ineligible patients identified after randomisation, 2 no-growth/no-fungi cases, 2 kit-unavailability cases, and 3 unevaluable cases. This imbalance introduces some risk of attrition-related distortion.
- Performance/Detection Bias: The trial was open-label, and study staff assessing deleterious events were not masked. Mortality is objective, but some DOOR components — unsuccessful discharge, lack of clinical response, and undesirable events — are more judgement-sensitive than death alone.
- Protocol Adherence: The intervention was delivered with clear laboratory separation: median time from Gram stain to AST result was 7.5 hours (IQR 1.3) with rapid AST versus 44 hours (IQR 23) with standard AST. Median time to first escalation or de-escalation was 22 vs 36 hours, confirming that the experimental process was genuinely different.
- Baseline Characteristics: Groups were broadly similar, but there were small numerical imbalances: immunocompromised patients were 26% in rapid AST vs 22% in standard AST; qPitt ≥2 was 22% vs 25%; hypotension or vasopressor requirement was 24% vs 28%; resistant organisms were 45% vs 41%. These differences were not obviously large enough to invalidate the trial, but they matter when effects are small.
- Heterogeneity: Site heterogeneity was substantial. Standard organism-identification turnaround ranged from 3 to 46.5 hours across centres, standard AST turnaround from 23 to 54 hours, and stewardship staffing/workflows also varied. This reflects real-world practice, but it dilutes a single, uniform estimate of effect.
- Timing: Randomisation had to occur within 16 hours of positivity, which is appropriate for a rapid phenotypic assay. However, 76 screened patients were excluded outside business hours, showing that enrolment and delivery remained partly constrained by local workflow.
- Dose: The diagnostic “dose” was a single direct-from-bottle phenotypic AST run plus stewardship input. The intensity of delivered intervention was reduced by off-panel organisms: on-panel organisms comprised 339/413 (82%) of rapid-arm patients and 353/437 (81%) of standard-arm patients; approximately one-fifth of analysed patients therefore had no full direct test target match. In addition, rapid-AST isolate results were missing in 29/442 (7%) isolates.
- Separation of the Variable of Interest: Laboratory separation was strong, but clinical separation was only moderate because many patients were already appropriately treated. Effective therapy at baseline was 254/413 (61.5%) in rapid AST vs 276/437 (63.2%) in standard AST. By 24 hours this separated to 83.5% vs 75.3%, but by 3 days it had narrowed to 88.4% vs 85.6%.
- Key Delivery Aspects: Both groups received active stewardship review. That is methodologically sensible and clinically realistic, but it means FAST tested the incremental value of faster susceptibility data on top of stewardship, not rapid AST versus routine care without stewardship support.
- Outcome Assessment: Mortality and discharge are objective; relapse, suppurative complications, seeding of distant sites, and hospital-acquired organism outcomes are more vulnerable to ascertainment and documentation differences between centres.
- Statistical Rigor: The planned evaluable sample size was achieved, the superiority criterion was prespecified, and the primary analysis followed the statistical analysis plan. The use of a modified intention-to-treat / as-randomised population was reasonable, but it is still less robust than a pure intention-to-treat analysis when exclusions are uneven.
Conclusion on Internal Validity: Internal validity is moderate. Randomisation was sound and laboratory/process separation was convincing, but the open-label design, composite DOOR endpoint, and unequal post-randomisation exclusions mean small between-group differences should be interpreted cautiously.
External Validity
- Population Representativeness: FAST included adults and children, but the analysed cohort was predominantly older adults (median age 72 years) treated in tertiary hospitals with blood culture capability, MALDI-ToF identification, and active stewardship teams. It is therefore more representative of referral hospitals than of smaller or infrastructure-limited centres.
- Applicability Across Systems: The multinational design is a major strength and captures genuine diversity in Greece, Israel, India, and Spain. However, the results are most applicable to hospitals facing high rates of resistant gram-negative bacteraemia and less applicable to lower-resistance environments where the biological opportunity for benefit is smaller.
- Infrastructure Dependence: Every participating site could implement rapid phenotypic AST and use MALDI-ToF for identification. Many low-resource hospitals cannot replicate that laboratory platform or provide near-real-time stewardship response.
- Therapeutic Availability: External validity is constrained by formulary realities. The trial itself highlighted aztreonam shortage in Greece and limited availability of newer first-line agents for carbapenem-resistant organisms in India and Greece. A rapid result is only clinically useful if the active drug can actually be given.
- Pathogen Mix: Off-panel organisms matter. Nearly one-fifth of analysed patients had off-panel organisms, and Salmonella Typhi was seen only in India and was not on the rapid panel; settings with more off-panel pathogens would likely derive less benefit.
Conclusion on External Validity: External validity is moderate and setting-dependent. FAST is most generalisable to tertiary hospitals with high antimicrobial resistance burdens, MALDI-based organism identification, and active stewardship programmes; it is less transferable to hospitals lacking those capabilities or those with very different pathogen ecology.
Strengths & Limitations
- Strengths:
- Large pragmatic multinational randomised trial in genuinely high-resistance settings.
- Meaningful laboratory separation between intervention and control, with rapid AST delivered in hours rather than days.
- Universal stewardship review in both arms, making the comparison clinically relevant and fair.
- Phenotypic rapid AST rather than a restricted genotypic resistance panel.
- Prespecified resistant-organism subgroup analyses that identified where benefit was most plausible.
- Limitations:
- Open-label design with unblinded assessment of several DOOR components.
- Modified intention-to-treat / as-randomised analysis with uneven post-randomisation exclusions.
- Substantial cross-site heterogeneity in standard microbiology, turnaround times, stewardship workflows, and antibiotic availability.
- Approximately one-fifth of analysed patients had off-panel organisms, and the rapid platform did not provide organism identification.
- Antibiotic regimens were not standardised and were influenced by local access and cost.
- No cost-effectiveness analysis.
Interpretation & Why It Matters
-
Clinical meaningFAST was a negative superiority trial for its primary 30-day patient-centred composite. Rapid AST did not improve the overall DOOR distribution, mortality, or overall length of stay in an unselected high-resistance bacteraemia population.
-
What FAST addsIt nevertheless showed that rapid phenotypic AST is clinically actionable: it accelerated antibiotic modification, increased effective therapy by 24 hours, increased stewardship contact and acceptance, and produced the clearest discharge-related signals in cephalosporin-resistant and carbapenem-resistant subgroups.
-
Practical significanceThe trial shifts the conversation from “Does rapid AST save lives in everyone?” to “In which patients and systems is faster phenotypic AST worth implementing?” The answer appears to be: where resistance prevalence is high, undertreatment risk is real, stewardship is responsive, and active drugs are actually available.
Controversies & Other Evidence
- Why was the primary endpoint neutral despite faster treatment changes?
- The accompanying editorial argued that any mortality signal was probably diluted because only roughly one-quarter of FAST participants had septic shock and more than 60% were already on effective therapy at enrolment; the subgroup most likely to benefit biologically — severe infection plus ineffective empiric therapy — was therefore relatively small. 4
- That explanation fits the observed pattern: the strongest benefits were in process measures and resistant-pathogen subgroups rather than in overall mortality.
- Was DOOR the right endpoint?
- DOOR is explicitly patient-centred because it integrates benefit and harm, but it compresses clinically different states into a single ordinal scale and can be harder to interpret than mortality or time-to-active-therapy alone. Methodological papers on DOOR have highlighted both its strengths and its interpretive pitfalls. 56
- In FAST, the primary DOOR result was neutral even though several individual process measures clearly improved, illustrating this tension directly.
- How does FAST compare with earlier randomised evidence?
- FAST broadly reproduced the pattern seen in RAPIDS-GN: faster microbiological actionability and earlier antibiotic optimisation, but no convincing mortality signal in the overall population. 1
- What FAST adds is external breadth: it tested the question in higher-resistance, multinational settings rather than mainly lower-resistance North American or European environments.
- What do broader evidence syntheses and guidance say?
- A recent network meta-analysis suggested that rapid diagnostic tests paired with stewardship may improve mortality and time to optimal therapy at a system level, and recent ASM laboratory medicine guidelines support rapid bloodstream diagnostics as part of structured laboratory–clinical workflows. FAST suggests that these benefits are contingent rather than automatic for every phenotypic AST implementation. 211
- Reviews of rapid AST implementation similarly emphasise that actionability, communication pathways, and stewardship responsiveness are the real mediators of clinical effect, not merely the machine turnaround time. 3
- Antibiotic access is a core modifier of benefit.
- FAST exposed a practical ceiling effect: faster susceptibility results cannot improve outcomes if the preferred drug is unavailable. Contemporary IDSA guidance prioritises newer active agents over polymyxins for several multidrug-resistant gram-negative syndromes, and access-focused commentary has argued that diagnostic expansion must be paired with equitable access and stewardship infrastructure. 78
- This matters directly for FAST because aztreonam shortage and limited access to newer carbapenem-resistant organism therapies likely blunted the trial’s achievable effect size.
- De-escalation may be the most clinically important downstream signal.
- Recent observational evidence associates de-escalation with lower odds of acute kidney injury, ICU admission, in-hospital mortality, and new gram-negative resistance. This does not prove causality for FAST, but it strengthens the plausibility that the trial’s earlier de-escalation could matter clinically even when mortality is unchanged in the parent trial. 910
- Subsequent adjacent randomised evidence remains cautious.
- Another pragmatic randomised trial of direct-from-blood bacterial testing in adults with suspected infection also showed much faster diagnostic information without shortening key antibiotic-duration endpoints, reinforcing the lesson that faster microbiology alone does not guarantee better clinical outcomes. 12
Summary
- FAST was a pragmatic, multinational, open-label randomised trial of rapid phenotypic AST in 850 analysed patients with gram-negative bacteraemia from high-resistance settings.
- The primary endpoint was negative: DOOR probability was 48.8% (95% CI 45.3 to 52.4), so rapid AST was not superior to standard AST for 30-day patient-centred outcomes.
- Rapid AST clearly improved treatment actionability: effective therapy within 24 hours was 83.5% vs 75.3%, and first escalation/de-escalation occurred 22 vs 36 hours after Gram stain.
- The strongest clinical signals were in resistant-pathogen subgroups, particularly fewer patients still hospitalised at day 30 with carbapenem-resistant infection and shorter post-enrolment stay in cephalosporin-resistant infection.
- The main message is not that rapid AST is useless, but that its benefit depends on who is being tested, how results are operationalised, and whether the right antibiotics are actually accessible.
Overall Takeaway
FAST is an important contemporary negative trial rather than a classic landmark efficacy study. It shows that rapid phenotypic AST can accelerate stewardship-relevant treatment optimisation in resistant gram-negative bacteraemia, but that faster susceptibility data alone does not reliably translate into better 30-day composite outcomes when many patients are already on active therapy and access to optimal drugs is imperfect.
Overall Summary
- Rapid AST did not improve the primary 30-day DOOR endpoint.
- It did accelerate antibiotic modification, active therapy at 24 hours, and stewardship uptake.
- The clearest signals of benefit were in resistant-organism subgroups and discharge-related outcomes.
Bibliography
- 1.Banerjee R, Komarow L, Virk A, et al. Randomized Trial Evaluating Clinical Impact of RAPid IDentification and Susceptibility Testing for Gram-negative Bacteremia: RAPIDS-GN. Clin Infect Dis. 2021;73(1):e39-e46.
- 2.Peri AM, Chatfield MD, Ling W, Furuya-Kanamori L, Harris PNA, Paterson DL. Rapid Diagnostic Tests and Antimicrobial Stewardship Programs for the Management of Bloodstream Infection: What Is Their Relative Contribution to Improving Clinical Outcomes? A Systematic Review and Network Meta-analysis. Clin Infect Dis. 2024;79(2):502-515.
- 3.MacVane SH, Dwivedi HP. Evaluating the impact of rapid antimicrobial susceptibility testing for bloodstream infections: a review of actionability, antibiotic use and patient outcome metrics. J Antimicrob Chemother. 2024;79(Suppl 1):i13-i25.
- 4.Srinivasan A. A Multinational Trial of Rapid Antimicrobial Susceptibility Testing: Is FASTer Better? JAMA. Published online April 18, 2026.
- 5.Evans SR, Rubin D, Follmann D, Pennello G, Huskins WC, Powers JH, et al. Desirability of Outcome Ranking (DOOR) and Response Adjusted for Duration of Antibiotic Risk (RADAR). Clin Infect Dis. 2015;61(5):800-806.
- 6.Ong SWX, Petersiel N, Loewenthal MR, Daneman N, Tong SYC, Davis JS. Unlocking the DOOR—how to design, apply, analyse, and interpret desirability of outcome ranking endpoints in infectious diseases clinical trials. Clin Microbiol Infect. 2023;29(8):1024-1030.
- 7.Tamma PD, Heil EL, Justo JA, Mathers AJ, Satlin MJ, Bonomo RA. Infectious Diseases Society of America 2024 Guidance on the Treatment of Antimicrobial-Resistant Gram-Negative Infections. Clin Infect Dis. 2024 Aug 7:ciae403.
- 8.Patel TS, Sati H, Lessa FC, Patel PK, Srinivasan A, Hicks LA, et al. Defining access without excess: expanding appropriate use of antibiotics targeting multidrug-resistant organisms. Lancet Microbe. 2024;5(1):e93-e98.
- 9.Kam KQ, Chen T, Kadri SS, et al. Epidemiology and outcomes of antibiotic de-escalation in patients with suspected sepsis in US hospitals. Clin Infect Dis. 2025;80(1):108-117.
- 10.Teshome BF, Park T, Arackal J, Hampton N, Kollef MH, Micek ST. Preventing New Gram-negative Resistance Through Beta-lactam De-escalation in Hospitalized Patients With Sepsis: A Retrospective Cohort Study. Clin Infect Dis. 2024;79(4):826-833.
- 11.Wolk DM, Parrott JS, Babady NE, Mochon AB, Tom R, Diel C, et al. The American Society for Microbiology’s evidence-based laboratory medicine practice guidelines for the diagnosis of bloodstream infections using rapid tests: a systematic review and meta-analysis. Clin Microbiol Rev. 2025;38(3):e00137-24.
- 12.Gaston DC, Humphries RM, Lewis AA, et al. Effect of Direct-from-blood Bacterial Testing on Antibiotics Administration in Adults Presenting With Acute Infection: A Randomized Trial. Clin Infect Dis. 2026;82(2):e227-e235.
Added April 18th, 2026